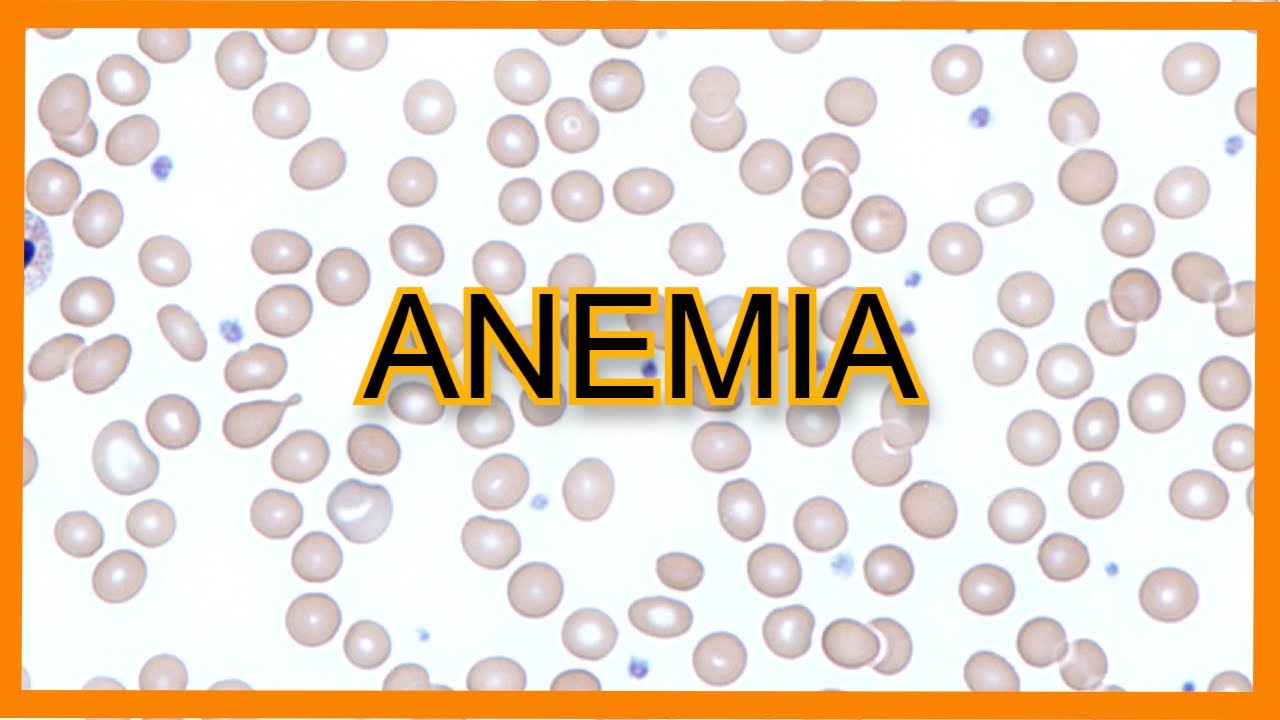
Anemia (Types, Findings, Lab Values)

se fala mais beleza aqui é o fixo eu sou os membros da mede 5 e hoje a gente vai aprender de uma maneira simples e didática como organizar os principais diagnósticos diferenciais de anemia pode desenhar muito bem antes de começar o vídeo não esquece de curtir o vídeo se inscrever no canal porque isso ajudando muito na divulgação então assim das anemias ele pode ser desafiador no início mas vocês vão perceber que se a gente seguir um caminho sequencial e lógico tudo vai ficar mais fácil eu vou começar com os sintomas da anemia então aqui a
gente vai dividir em duas colunas em uma nós vamos colocar os valores de hemoglobina e não uso nós vamos colocar os sintomas geralmente a hemoglobina maior que 3 em homens e maior que 12 mulheres é considerada normal ou seja mas não vamos ver sintomas quando temos a hemoglobina maior que 10 provavelmente também vamos ver os sintomas agora quando chegarmos à 8 e 9 de hemoglobina vamos começar a ter sintomas como mal-estar fadiga sabe aquela pessoa que nunca consegue terminar que está fazendo fala que sente mais fraca sem vontade onde chegamos às seis e sete de
hemoglobina vamos ter sintomas dispneicas e até os casos de perda de consciência quando nós chegamos há quatro ou cinco de hemoglobina o mais baixo o nosso paciente vai ter um risco muito elevado de alto então aqui é o emergencial que ele precisa transferir o mais rápido possível e donde uma frase que você vai levar para o raciocínio das anemias é que os sintomas depende dos valores da hemoglobina e não deve teologia da anemia em outras palavras anemias por diferentes tecnologias podem ter os mesmos sintomas e quanto mais rápido e se aquela da hemoglobina piores são
os sintomas que nós temos menos tempo por organismo se adaptar as bem comigo vamos entender os sintomas então basicamente você tem que entregar oxigênio a todas as células do seu corpo e por isso eu fascinante por exemplo nesse exato momento você tem uma massa que tá passando pela sua horta e ela vai entregar oxigênio lá para o dedão do seu pé mas então outra no raciocínio oxigênio que a gente entrega ele é igual ao débito cardíaco mesmo tanto de hemoglobina que nós temos vezes o tempo de oxigênio que as hemoglobinas estão carregadas então é basicamente
a saturação de oxigênio imagina comigo por acaso os níveis de hemoglobina diminui o corpo vai tentar compensar e isso aumentando o débito cardíaco ou entregar oxigênio para o corpo e aí aumentar o débito cardíaco o corpo aumento do batimento do coração então aqui a taquicardia vai ser um sinal de anemia em nada é tão ruim que não pode piorar com os dentes de hemoglobina continuam caindo nós perdemos um pouco a coloração da pele e das mucosas então apresentamos a palidez tá muito bem vamos para sequência de diagnóstico então quando você suspeitar de uma anemia é
só um hemograma e confirme sua suspeita muito e vamos alimentam os valores diminuídos de hemoglobina agora você vai pedir duas coisas o volume corpuscular médio das hemácias e o índice de reticulócitos normalmente isso já tem da hemograma mas tem em mente que você deve olhar e aqui mas vamos dividir em três categorias as anemias microcíticas em que o vcm ripper tenta as anemias macrocíticas em que o vc n vai ser maior que 100 e aquelas que estão entre 80 e 100 que vão ser as normas jurídicas tá quanto o valor que pode nos ajudar no
raciocínio é o índice de reticulócitos então fica mais fácil vamos desenhar o meu macho sendo destruída e uma medula em geral quando o índice de reticulócitos é maior que 2 e senti uma linha hiperproliferativa que a medula tá tentando repor essas e mas que foram apreendidas por causa da extinção ou por causa uma perda sanguínea mas quando esse índice de reticulócitos é menor que 2 são todos na mente vai indicar um problema na produção então lá na fábrica lá na medula e eu estou falando isso porque a maioria das anemias da sua prática que se
apresentar em como microcíticas uma croche dicas vão ser um problema de produção ou seja vão ter um índice de reticulócitos o menor que 2 enquanto a maioria das normocíticas elas vão ser vistas de um as podem ser natural na produção ou podem ter no programa na descrição mas fica tranquilo dote nós vamos detalhar cada um desses ramos começando pelas máquinas físicas é muito bem como vai acontecer tudo isso vamos pegar novamente paciente com sintomas de anemia quando pediram hemograma e perceber que a hemoglobina está abaixo dos valores normais além disso você vai olhar para o
volume corpuscular médio 10 hemácia e vai perceber que está acima de 100 às vezes muito acima de sim ou seja estamos diante de uma anemia macrocítica após isso vamos dividir assim megaloblásticas não mieloblasticas mas como você faz isso então basicamente as megaloblásticas não ter neutrófilos segmentados lá no esfregaço e massas então se você não achar esses neutrófilos segmentados não temos uma anemia megaloblástica e a maioria das pessoas tende a se confundir com esses temos fica assim macrocítica quer dizer um problema é o tamanho das hemácias enquanto megaloblástica quer dizer um problema de visão de dna
nós temos duas causas principais de anemia megaloblástica que são a deficiência de b12 e a deficiência de folato e nas causas não megaloblástica eu quero que você grave as doenças hepáticas o alcoolismo algumas drogas e doenças metabólicas vamos começar pela deficiência de ácido fólico podemos até falar com folículo porque ele está presente nos foliáceos as folhas verdes e nós temos um estoque de 36 meses de ácido fólico em doc não importa quanto você coma são apenas seis meses de ácido fólico então algumas vezes esse número pode estar baixo por uma alta demanda do corpo físico
na gravidez a causa mais comum de deficiência de ácido fólico para o alcoolismo para aqueles pacientes que bebem muito e acabam se alimentando muito bem principalmente nas folhas verdes o tratamento normalmente é empírico com a reposição do ácido fólico porém aqui se você procurar no livro vai perceber que ele cita 2 exames de laboratório estão os negros de um passo metilmalônico o joão system então nesse primeiro caso nós vamos ter níveis normais de ácido metilmalônico mas já os níveis de um sistema vão estar no vaso é que existe um problema com um sistema já que
ela se eleva tanto na deficiência de ácido fólico como na deficiência de b12 e o como nacional de diagnóstico depende muito de diferenciar o ácido fólico da b12 ela acabaram ajudando muito mas como alguns professores até provas cobram tens com sentimentos vamos para a deficiência de b12 já que nós temos stocks para 3 a 10 anos então a gente todos os anos que harry potter possam na escola você tem de estoque dv12 e ao contrário do ácido fólico a b12 ela vem de alimentos de origem animal então tem em mente que é muito difícil ter
uma deficiência de b12 você pode até ter grupos grupos específicos como veganos mas em geral é bem difícil o diferencial dessa doença são os sintomas neurológicos que ela pode causar como parestesias sensação de formigamento no quadro temos nós podemos até ter uma confusão mental bom então basicamente na sua prática vão ser 3.3 perfis de pacientes o principal paciente com diagnóstico de anemia perniciosa temos o com doença de crohn e aqueles com by-pass gástrico o diagnóstico ele é feito mediante dos níveis de b12 se eles estiverem em baixo você pode tratar os níveis de ácido metilmalônico
ea homocisteína que nós já falamos eles vão estar altos na deficiência de b12 então vamos conversar um pouquinho sobre as patologias apresentadas vamos desenhar aqui o estômago e intestino delgado muito bem as células parietais do estômago elas produzem o fator intrínseco e esse fato e se liga bem doce vocês tirando a dieta formam um complexo e esse complexo acaba sendo um serviço lá no edital então coloque você deve ter um estômago funcionante e um livro digital funcionante para absorver a b12 bom então não me atende ciosa nós temos um ataque demônio as células parietais do
estômago ou seja nós perdemos a capacidade de formar fator intrínseco à doença de crohn mas temos uma inflamação geralmente no íleo terminal então por isso nós temos problemas na absorção de b12 por último aqueles com by-pass gástrico eles não tem o alimento passando diretamente pelo estômago e eles foram menos essa combinação de b12 e com o fator intrínseco tu vai acabar dinheiro nosso tratamento para sempre se você tem um paciente com problemas na absorção administração dp12 entramos colar agora se você tem um paciente com deficiência alimentar de b12 a administração pode ser oral nas causas
não melhor básicas mas vamos ter basicamente é cirrose drogas como os agentes quimioterápicos os antiretrovirais e algumas síndromes metabólicas mais raras e que a gente não precisa perder tempo detalhando cada uma delas isso é basicamente que você tem que saber na prática do sonen bom então bora para as micro se dicas bem dog estamos nas anemias microcíticas novamente a gente vai colocar aqueles clientes canto então um paciente com sintomas anemia você perde o hemograma olha hemograma e percebe que tem uma anemia vamos olhar para os para o volume corpuscular médio e perceber que o valor
está menor que 80 história estamos diante de uma anemia microcítica aqui os testes mais vão te ajudar no diagnóstico são os da cinética do ferro e doc se tiver que escolher apenas um escolhe a sua retina não pensei duas vezes então vamos fazer um resuminho eu vou desenhar aqui um trem e seus vagões vamos imaginar no conteúdo dos vagões vai ser no ferro que vai ser transportado o número de vagões é a sua retina e o número de lagoa socopas é a saturação de transferrina e o lugar de onde sai tudo todo fé podemos colocar
como por exemplo uma fábrica vai ser a frente ainda e eu gosto de pensar assim porque deixa o raciocínio mais palpável ele também te ajuda a entender as patologias relacionadas ao ferro então a causa mais comum de anemia no mundo é anemia ferropriva ela causa mais com das microcíticas ela causa mais comum das normas éticas agora a causa mais comum de anemia ferropriva são sangramentos crônicos vamos entender estoque a dieta normal no brasileiro ela contém 5 a 10 mg de ferro e nós observamos apenas metade disso agora a cada 10 ml de 100 contém 5
mg de ferro ou seja tumores menstruações úlceras elas podem sangrar bem mais que isso e a gente pode perder muito mais perto do que absorve por isso o perfil de paciente vai ser um homem com mais de 60 anos como possível turma intestinal e eu ou uma mulher jovem tem um quadro de menorragia o diagnóstico é feito pela cinética do ferro bom então o ferro sérico vai estar baixo à frente de china vai estar baixa a transferrina vai estar alta e o tratamento vai ser com reposição de ferro a dose recomendada para correção da anemia
ferropriva é de 60 mg de ferro elementar estudar mais ou menos uns 300 mg de sulfato ferroso para não sabe o desenho para entender melhor então vamos ter pouco ferro na fábrica e pouco ferro dentro dos vagões contudo nós vamos aumentar os números de vagões para tentar entregar mais ferro e agora indo para as anemias por doença crônica o desenho mudou um pouco o fígado ele produz uma proteína chamada hepcidina essa proteína meio que tranca fábrica e reduz o número de vagões ou seja vamos ter uma ferritina alta e um ferro sérico baixo e transferir
uma abaixo é geralmente um paciente com doença crônica é aquele que tem artrite reumatóide lúpus ou outra doença inflamatória crônica e na maioria esmagadora das vezes eles são assintomáticos ou seja o tratamento vai ser corrigir a doença de base corrigir somatório de corrigir o lupus em alguns casos específicos existe tratamento com eritropoetina mas tem mente que na maioria das vezes novamente vai ser tratado doença de base nas talassemias nós temos um problema com a globina diferente da anemia ferropriva e por doença crônica que são problemas do grupo e me aqui em outra proteína na globo
temos dois tipos de paciente os contá-la ser minha mina que serão em que serão e maioria assintomáticos e aqueles como talassemia maior que serão esqueceram aqueles que precisarão de tratamento precisarão de repetir as transfusões de sangue a gente uma maneira muito legal para resumir as talassemias e provavelmente na aula você aprendeu sobre isso g o prefeito 11 ausência dele mas é que a gente vai considerar todos os genes pés como defeituosos ou não vamos desenhar aqui uma linha vamos colocar as cadeias alfas e as cadeias betas muito bem nós só temos duas betas possíveis para
formar uma mina então um paciente sem o gene para cadeia alfa provavelmente ele vai ser assintomático no entanto quando perdemos dois dias para cadeia alfa nós vamos ter uma talassemia minor isso também vale para perder de um gene da cadeia aberta quando nós perdemos três genes da cadeia alfa vamos ter uma talassemia maior isso vale para quando perdemos dois genes da cadeia aberta agora quando esperamos quatro genes da cadeia alfa nós não nascemos isso é incompatível com a vida então o principal exame aqui da sala as fêmeas de longe vai ser eletroforese de hemoglobina e
sobre o tratamento aqueles indivíduos com talassemia menor geralmente eles são assintomáticos não vou precisar de tratamento agora aqueles conta assim e eles vão precisar de transfusões repetidas de sangue e aqui tá uns mais problemas de vida essas transfusões repetidas vezes indivíduos podem desenvolver um quadro de acúmulo de ferro como uma hemocromatose secundária transfusão então por isso o tratamento vai ser administração de quelantes de ferro e aí você se pergunta por que não fazer a fé botou mia oi e a resposta até simples esses pacientes eles fazem transfusão porque ele já estão com pouco sangue e
por isso a fé botou mina é tão preconizado fechando vamos falar se uma linha mais rara que é ácida ou básica aqui a cinética do ferro vai ser mais ou menos assim o ferro sérico alto ele tinha aumentada e o resto pode variar de um problema na mitocôndria que faz com que o ferro tá com ele por volta dela e o que você mais vai ser cobrado é sobre as causas reversíveis e irreversíveis dessa anemia nas causas reversíveis nós temos medicamentos principalmente os usados no tratamento da tuberculose temos o álcool e temos o chumbo nas
causas irreversíveis nós temos as síndromes mielodisplásicas a deficiência de b6 que não melhoram com reposição de b6 e um dado de prática é que nós vamos se encontrar se ter o braço sem anel nessa doença muito bem eu sei que são muitos detalhes mas vai mantendo tudo que a gente vai passar fazendo em minhas normocíticas o bem do que estamos no final mas aqui a gente vai falar das anemias normocíticas e vamos falar basicamente nas anemias hemolíticas e eu vou te explicar o porquê disso primeiro vamos fazer essa sistema novamente você tem um paciente com
sintomas de anemia pede um hemograma olha hemoglobina está baixa olha para o vcm e ver que está normal ou às vezes até um pouquinho elevado muito bem temos uma anemia normocítica clicar temos muitas causas e aqui muitas causas mesmo realmente você vai encontrar na sua prática causas relacionadas a doenças crônicas hepatopatias especie renal mas aqui o como objetivo é organizando a sua mente mas vamos falar mais simples anemias hemolíticas mas uns que já é basicamente três exames que o ldh é uma enzima diferença né márcia a haptoglobina é uma proteína que diminui quando ligado à
hemoglobina ea bilirrubina então nesse caso nós vamos ter um aumento do ldl haptoglobina vai estar baixa e os níveis de brilho a minha música agora se esses níveis estiverem normais cara tô mente está falando de uma hemorragia agora dificilmente vai ser um diagnóstico que você não saiba que você consegue ver o mesmo agir agora outro dado que nós temos que olhar é o esfregaço de sangue eu digo isso porque se vierem resultados normais para anemia hemolítica o esfregaço pode nos dar alterações que podem sugerir uma melo displasia e lance é mesmo parecendo um aparecimento de
células jovens no esfregaço vamos começar com anemia falciforme e doc é uma doença com vários detalhes então tem em mente que a gente vai resumir mais voltado para hematologia então o perfil do paciente é aquele que tem uma crise vaso-oclusiva e o que isso quer dizer não aumente nós temos uma hemácia que passa sem problemas no vaso agora em períodos de acidose hipóxia e desidratação essas ela tende a mudar a conformação o formato de foice e aqui nós temos basicamente dois caminhos ou essas células sofre uma hemólise ou ela vai ocluir o vaso o diagnóstico
geralmente é feito o lado do teste do pezinho lá quando o neném nasce e o tratamento ele é feito com o hidroxiuréia essa substância tem duas a formação da hemoglobina fetal essa hemoglobina ela tem duas cadeias alfa cê dos cabelos deltas ela não tem problema de gerais conformação de foice porque eles são problema da cadeia aberta com as crises são causadas por desidratação e hipóxia e acidose o tratamento vai ser hidratação oxigênio e controle da dor e algumas vezes paciente vão precisar de transfusão isso um objetivo de trocar essas células em formato de foice para
células de formato normal é muito bem a próxima doença vai ser a deficiência de g6pd então basicamente foi uma pessoa tenha se em cima não existe alguma stress oxidativo dentro das hemácias não acontece muita coisa agora indivíduos que não tenha cima não consegue lidar bem com o stress oxidativo então quando ele acontece a célula tende a romper as finalize o perfil do paciente vai ser um indivíduo do sexo masculino e ingeriu algum medicamento que geralmente eles colocam nitrofurantoína o bactrim a da piscina o diagnóstico é feito pelos níveis de g6pd mas tenha em mente que
esses níveis ele só cai seis a oito semanas depois da crise aguda e o tratamento é a simples retirada da medicação e evitar de ingerir essa medicação do futuro pode ser muito bem vamos para esferocitose hereditária essa doença causa problemas nas proteínas do citoesqueleto da hemácia então o perfil do paciente é aquele que se apresenta com hemólise e esferocitose é um negócio mais laboratorial funciona mais ou menos assim tínhamos o vaso comer massa passando normalmente e na esferocitose nós temos uma hemácia redonda ela não consegue se de formar direito então quando ela chega no baço
o baço olha para ela ver que ela não consegue se deformar e elimina causando é mole esse então o diagnóstico é feito basicamente no esfregaço de massas só que a prova gosta de comprar um teste um teste mais específico é chamado de fragilidade osmótica ele também é usado para diagnosticar os próximos o tratamento é a retirada do baço esplenectomia e cara isso não vai curar doença você vai continuar atender massas em formato de espera porque isso vai prender aí mose e aumenta a vida desse paciente por último para fechar o vídeo vamos falar das anemias
hemolíticas auto-imunes e norte pense no teste de coombs direto positivo no teste de coombs direto positivo vai ser igual anemia hemolítica auto-imune e aqui se o curso for positivo para a ii gm estamos falando de anticorpos frios e o tratamento vai ser evitar o frio isso não temos muitos muitos problemas aqui agora se o teste coombs for positivo para igg nós temos frente para os chamados de anticorpos quentes ó e esses corpos estão relacionados a doenças autoimunes como lúpus e as neoplasias e como não temos como evitar calor nós vamos ao tratamento medicamentoso e geralmente
é feito com corticoides é muito bom doc a gente tentou resolver aqui a maioria das anemias é não esqueça de deixar o comentário que você achou se quer mais resumos rápidos como esses ou se prefere um resumo maior um resumo de uma hora para fechar eu reservei algumas questões no final mas a gente só vai olhar o perfil do paciente e o tamanho das hemácias para fechar o diagnóstico quero te mostrar como fica mais fácil raciocínio se souber organizar melhor na mente os diagnósticos de anemias vem comigo isabel 50 anos histórico de cirurgia bariátrica uma
mexeu no estômago deve ter me dito alguma coisa do fator intrínseco a gente olha por vcm e ver que é 120 ou seja barcos sem é uma anemia macrocítica se já chega olha para as opções e ver deficiência de b12 essa observação resposta é bom para próxima mulher de 28 anos previamente ida aí você olha para ver cm tá de 106 se olhar macrocitose e olha hipersegmentação de neutrófilos é uma anemia megaloblástica das opções só deficiência de b12 poderia ser também uma deficiência de folato a gente não tem nas alternativas é bom para outra questão
nós temos um paciente agora de 88 anos com anemia macrocítica e com parestesia de membros não precisa nem pensar né porque isso vai ser com deficiência de b12 então a gente marca hidroxicobalamina e vamos para a próxima cinco anos de idade aparência anêmica sério pego bobina seis e meio realmente ele tá com anemia ele tem um exame de coombs direto positivo com os direto positivo igual a anemia hemolítica auto-imune não precisa pensar muito doc é só marcar porque você tem organizado na sua mente de uma maneira simples e didática os diagnósticos de alimentos então era
isso não esquece de curtir e comentar qualquer dúvida a gente responde nos comentários abraço tchau